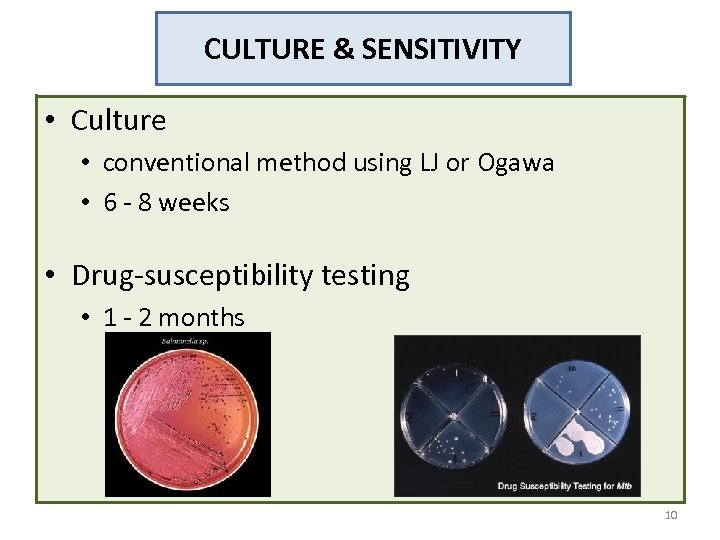
CULTURE & SENSITIVITY • Culture • conventional method using LJ or Ogawa • 6

3d4d81bbf9423fff6045cfe74bcd1c9e.ppt
- Количество слайдов: 22

TB – LABORATORY INVESTIGATIONS by Dr. Zubaidah Abdul Wahab Datin Dr. Ganeswrie Raj 1

LEARNING OBJECTIVES • To update current laboratory investigations & techniques for diagnosing TB • To strengthen laboratory facilities for TB management 2

INTRODUCTION • Diagnosis of TB is based on the detection of acid fast bacilli (AFB) on smears & culture of Mycobacterium tuberculosis from clinical specimens. 3

INTRODUCTION • Specimen collection • Lab investigations – Microscopy – Culture – Identification – Anti. TB sensitivity – Molecular 4

SPUTUM COLLECTION • Sputum 1 • At least 2 specimens • At least one early morning specimen • For patients who are unable to spontaneously expectorate adequate sputum specimens • Sputum induction with nebulised hypertonic saline • Fiberoptic bronchoscopy with bronchoalveolar lavage • Gastric lavage especially in paediatric group (neutralise with sodium bicarbonate) 1 WHO, 2010 5

OTHER SAMPLES • Sterile body fluids • include blood, CSF, pleural fluid, peritoneal fluid • should be collected aseptically • transported immediately to laboratory in sterile container - 6

MICROSCOPY • Microscopy • • Presumptive diagnosis Sputum Ziehl-Neelsen staining for AFB Conventional microscope • low sensitivity (20 - 60%)1 • Light emitting diode-based fluorescence microscopy (LED FM)2 • 10% more sensitive • shorter time spent • quicker turnaround time 1 Steingart KR et al. , Lancet Infect Dis, 2006 2 Shenai S et al. , Int J Tuberc Lung Dis, 2011 7

CONVENTIONAL LIGHT MICROSCOPY Acid fast bailli

IMMUNOFLUORESCENCE MICROSCOPY AFB bacilli – IF stain (low mycobacterial load)
CULTURE & SENSITIVITY • Culture • conventional method using LJ or Ogawa • 6 - 8 weeks • Drug-susceptibility testing • 1 - 2 months 10

PHENOTYPIC METHOD – Proportion method A B Susceptible to INH M. tuberculosis Without drug With drug - INH

Conventional culture medium (solid) – TB. Rough, buff, cream-coloured colonies, compact, corded colonies

CULTURE & SENSITIVITY • Liquid culture media a. Bactec MGIT - detection by 2 weeks - identification within 3 weeks - sensitivity testing by 4 weeks b. Bactec Myco. F only for blood sample 13

NUCLEIC ACID AMPLIFICATION TEST (NAAT) • NAAT • molecular technique • provide rapid results within 24 - 48 hours • ability to confirm presence of Mycobacterium in 50 80% AFB smear negative & culture positive 1, 2 • detect Mycobacterium in specimens weeks earlier than culture for 80 - 90% patients 2 1 CDC, MMWR Morb Mortal Wkly Rep, 2009 2 Sarmiento OL et al. , J Clin Microbiol, 2003 14

LINE PROBE ASSAY (LPA) • Line Probe Assay (LPA) • detect rifampicin & isoniazid resistance in smear positive sputum or culture isolates • carried out in a TB risk level 2 laboratory 15

GENE XPERT MTB • Gene Xpert MTB • for detection of rifampicin resistance Mycobacterium • fast & accurate • can be used in peripheral laboratories • fully automated, near the patient, uses a robust system & technically simple 16

17

COMMERCIAL SEROLOGICAL ASSAY • Recommendation 5 Commercial serological assay should not be used to diagnose pulmonary & extrapulmonary TB. 18

COMMERCIAL SEROLOGICAL ASSAY • WHO published a policy statement in 2011 stating that commercial serological tests for TB provides inconsistent & imprecise estimates of sensitivity & specificity which can adversely impact patient safety. 1 1 WHO, Commercial serodiagnostic tests for diagnosis of tuberculosis, 2011 19

ROLE OF ADENOSINE DEAMINASE (ADA) IN TB DIAGNOSIS • ADA is an enzyme involved in purine metabolism of the cells. • Measurement of ADA level in pleural effusion & CSF is useful additional test in pleural & meningeal TB. • In pleural TB, sensitivity = 92% & specificity = 90%1 • In CSF-ADA in TB meningitis, sensitivity = 93% & specificity of 97% if cut-off level of >10 U/L used 2 1 Liang 2 Rana QL et al. , Respir Med, 2008 SV et al. , Clin Neurol Neurosurg. , 2010

TAKE HOME MESSAGES • LED FM has more advantages than conventional microscopy • NAAT e. g. LPA is able to shorten the turnaround time for identification & anti. TB testing • Measurement of Adenosine Deaminase level in pleural or cerebrospinal fluid may be considered as an adjunct in diagnosing pleural TB & tuberculous meningitis respectively. 21

THANK YOU Ødr_zubaidah@sel. moh. gov. my Øganiraj_balan@yahoo. com 22
3d4d81bbf9423fff6045cfe74bcd1c9e.ppt